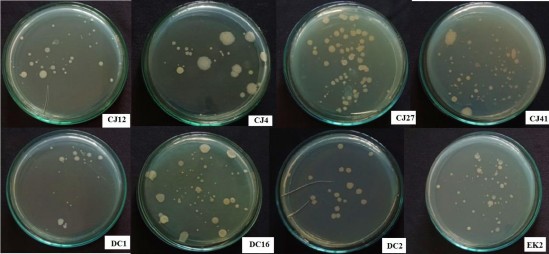
Hình 3 8 Mật độ vi sinh vật tổng số trong đất hồ tiêu ở các nghiệm thức 3

p<0,01. Cây hồ tiêu vườn ươm được xử lý với các chủng vi khuẩn vùng rễ hầu hết đều có ảnh hưởng tích cực đến hàm lượng diệp lục a, diệp lục b so với hai nghiệm thức đối chứng ĐC1 và ĐC2. Hàm lượng diệp lục a tăng từ 10,00% đến 53,33% và hàm lượng diệp lục b tăng từ 23,53% đến 117,64% trong đó nghiệm thức RB.EK2 có hàm lượng diệp lục a và b cao nhất, tiếp theo là nghiệm thức RB.DS29, RB.BH15 và RB.CS1.
Bảng 3.7. Ảnh hưởng của chủng vi khuẩn đến sinh trưởng rễ của cây hồ tiêu sau 90 ngày lây nhiễm Phytophthora
Chiều dài rễ (cm) | Khối lượng rễ (g) | Mật độ vi sinh vật tổng số (x106CFU/g đất) | |
RB.EK4 | 16,65±2,79a | 1,35±0,17 | 4,70±2,15c |
RB.CJ35 | 13,95±2,31ab | 1,18 ±0,06 | 3,97±0,59c |
RB.EK2 | 16,57±1,46ab | 1,05±0,34 | 9,37±3,11b |
RB.CP15 | 16,44±1,86ab | 1,20±0,08 | 5,87±0,55bc |
RB.DS29 | 13,95±3,73ab | 1,20 ±0,32 | 15,27±0,51a |
RB.CS1 | 13,96±3,66ab | 1,07 ±0,56 | 5,03±2,00c |
RB.BH15 | 14,36±1,50ab | 1,33±0,31 | 6,53±0,95bc |
ĐC 1 | 13,61±0,72 ab | 1,33±0,21 | 3,20±0,70c |
ĐC2 | 12,59±1,05b | 0,97±0,31 | 1,90±0,10c |
P | * | ns | ** |
CV% | 15,85 | 23,27 | 24,72 |
Có thể bạn quan tâm!
-
Chương Trình Pha Động Trên Cột C18 -
Quy Trình Phân Tách Các Hợp Chất Vk01, Vk02, Vk03 Và Vk05 -
Hiệu Quả Kháng Phytophthora Capsici Trên Đoạn Thân Hồ Tiêu -
Ảnh Hưởng Của Chủng Vi Khuẩn Đến Một Số Chỉ Tiêu Sinh Trưởng Và Kháng Bệnh Của Cây Hồ Tiêu Sau 120 Ngày Lây Nhiễm Nấm Fusarium -
Định Danh Các Chủng Có Tiềm Năng Kháng Phytophthora, Fusarium, Kháng Tuyến Trùng Meloidogyne Gây Bệnh Rễ Ở Cây Hồ Tiêu -
Ảnh Hưởng Của Ph Đến Sinh Trưởng Của Chủng Rb.ds29, Rb.cj41 Và Rb.ek7
Xem toàn bộ 224 trang tài liệu này.
Ghi chú: ĐC1: Đối chứng không lây nhiễm đoạn thân với Phytophthora; ĐC2: Đối chứng lây nhiễm đoạn thân với Phytophthora; ns: khác biệt không có ý nghĩa thống kê ở mức p<0,05, * Khác biệt có ý nghĩa thống kê ở mức p<0,05, ** Khác biệt có ý nghĩa thống kê ở mức p<0,01, các chữ cái giống nhau trên cùng một cột thể hiện sự khác biệt không có ý nghĩa thống kê theo trắc nghiệm phân hạng Duncan’s Multiple Rang Test.
Đối với một số chỉ tiêu sinh trưởng rễ của cây hồ tiêu, kết quả bảng 3.7 cho thấy các chủng vi khuẩn cũng tác động đến chiều dài rễ và khối lượng rễ tươi của cây hồ tiêu. Khả năng phát triển của bộ rễ cây hồ tiêu giữa các nghiệm thức thí nghiệm, khối lượng rễ và chiều dài rễ ở các nghiệm thức trong cùng một điều kiện thí nghiệm xử lý với các chủng vi khuẩn không có sự khác biệt về mặt thống kê. Chiều dài rễ dài nhất ở nghiệm thức RB.EK4 (16,65 cm) thấp nhất ở nghiệm thức RB.CJ35 và RB.DS29 (13,95 cm). So với nghiệm thức ĐC1 và ĐC2 chiều dài rễ lần lượt tăng
22% và 31%. Sở dĩ như vậy là do ảnh hưởng của Phytophthora đến bộ rễ, làm rễ nhiễm bệnh, hư hại dẫn đến sự kéo dài rễ kém.
Khối lượng rễ ở các nghiệm thức không có sự khác biệt có ý nghĩa thống kê. Tuy nhiên, cũng có thể thấy rằng, khối lượng rễ ở các nghiệm thức xử lý với vi khuẩn đều tăng gấp từ 1,11 đến 1,40 lần so với ĐC2 (không xử lý vi khuẩn, xử lý nấm). Khi so sánh chiều dài rễ và khối lượng rễ của các chủng vi khuẩn với ĐC1 (không xử lý vi khuẩn, không lây nhiễm nấm) có thể thấy một số chủng như: RB.EK4, RB.EK2, RB.DS29, RB.BH15 không chỉ giúp cây hồ tiêu kiểm soát ảnh hưởng của nấm bệnh mà còn kích thích bộ rễ sinh trưởng tốt hơn. Để khẳng định thêm điều này, nghiên cứu tiến hành đánh giá mật độ vi sinh vật tổng số trong đất cây hồ tiêu vườn ươm. Kết quả cho thấy, mật độ vi sinh vật tổng số có sự khác biệt có ý nghĩa thống kê giữa các nghiệm thức ở mức p<0,01. Trong các nghiệm thức xử lý với vi khuẩn, nghiệm thức RB.DS29 có mật độ vi sinh vật tổng số cao nhất (15,27 x106CFU/g đất), gấp từ 4,77 đến 8,04 lần so với đối chứng 1 (ĐC1) và đối chứng 2 (ĐC2) và gấp từ 1,63 đến 3,84 lần so với các nghiệm thức còn lại.
Bảng 3.8. Ảnh hưởng của chủng vi khuẩn vùng rễ đến một số chỉ tiêu sinh trưởng và kháng bệnh của cây hồ tiêu vườn ươm sau 90 ngày lây nhiễm Phytophthora
Chiều cao cây (cm) | Số rễ | Tỷ lệ rễ bệnh (%) | Tỷ lệ chết (%) | Mật độ Phytophthora (x101 CFU/g) | |
RB.EK4 | 41,30±4,99a | 4,67±0,59a | 16,00±0,03b | 20,00±0,07bc | 2,12 |
RB.CJ35 | 31,50±9,34ab | 3,33±0,64bc | 24,33±0,13a | 37,67±0,04a | 4,76 |
RB.EK2 | 33,90±5,26ab | 4,67±0,07a | 15,67±0,02b | 13,00±0,04cd | 11,00 |
RB.CP15 | 35,40±8,65ab | 4,33±0,30ab | 15,67±0,05b | 26,67±0,07ab | 2,03 |
RB.DS29 | 42,80±3,49a | 5,00±0,37a | 14,33±0,03bc | 9,00±0,04cd | 10,50 |
RB.CS1 | 32,70±6,42ab | 4,00±1,12ab | 16,33±0,06b | 33,33±0,07ab | 16,80 |
RB.BH15 | 38,70±6,71a | 5,00±1,17a | 15,33±0,01b | 11,00±0,04cd | 8,02 |
ĐC 1 | 29,37±8,31ab | 4,33±0,54ab | 11,33±0,10b | 4,33±0,08d | 2,34 |
ĐC2 | 19,33±7,49b | 2,33±0,89c | 23,68±0,22a | 33,33±0,07ab | 17,10 |
P | ** | * | ** | ** | |
CV% | 21,09 | 1,09 | 11,17 | 25,32 |
*Ghi chú: ĐC 1: Không lây nhiễm nấm bệnh, không xử lý vi khuẩn, ĐC 2: lây nhiễm nấm bệnh, không xử lý với vi khuẩn; * Khác biệt có ý nghĩa thống kê ở mức p<0,05, ** Khác biệt có ý nghĩa thống kê ở mức p<0,01, các chữ cái giống nhau trên cùng một cột thể hiện sự khác biệt không có ý nghĩa thống kê theo trắc nghiệm phân hạng Duncan’s Multiple Rang Test.
Kết quả bảng 3.8 cho thấy các chủng vi khuẩn tuyển chọn đều ảnh hưởng tích cực đến sinh trưởng của cây hồ tiêu trong vườn ươm sau 90 ngày lây nhiễm nấm bệnh với chiều cao cây tăng từ 62,96% đến 121,42 % so với ĐC2 (hình 3.6) và tỷ lệ rễ bị bệnh giảm từ 23,68% (ĐC2) xuống 14-16%, tỷ lệ chết giảm từ 3,3% (ĐC2) xuống 9,0-26,6% và mật độ Phytophthora trong đất giảm từ 17,10 CFU/g xuống 2,03 -16,80 CFU/g ở các nghiệm thức có xử lý chủng, sự khác biệt về sinh trưởng và tỷ lệ rễ bị bệnh, tỷ lệ chết ở các nghiệm thức là có ý nghĩa thống kê với p<0,01 (**). So sánh trong bảy chủng thử nghiệm, chủng RB.DS29 có hoạt tính vượt trội hơn so với các chủng còn lại. Vì vậy, chủng này được lựa chọn cho các nghiên cứu tiếp theo.

Hình 3.6. Chiều cao cây hồ tiêu sau 90 ngày lây nhiễm với nấm bệnh
Từ các kết quả đạt được khi đánh giá ảnh hưởng của các chủng vi khuẩn vùng rễ cây hồ tiêu đến sinh trưởng cũng như khả năng kháng bệnh chết nhanh do Phytophthora gây ra trên cây hồ tiêu. Nghiên cứu của chúng tôi đã góp phần chứng minh khả năng kháng nấm bệnh cũng như kích thích sinh trưởng cây trồng của các chủng vi khuẩn vùng rễ cùng với các nghiên cứu khác trên thế giới như nghiên cứu của Huang và cộng sự (2017), Jiang và cộng sự (2018), Zhang và cộng sự (2016), Meng và cộng sự (2016). Huang và cộng sự (2017) đã nghiên cứu khả năng kiểm soát Rhizoctonia solani và thúc đẩy sinh trưởng cây ớt (Capsicum annuum) của chủng Bacillus subtilis SL-44 [144]. Chủng này được phân lập từ vùng rễ cây ớt. Kết quả thí nghiệm trong chậu cho thấy, khối lượng khô và tươi của cây ớt khi lây nhiễm với nấm Rhizoctonia solani (SR) và chủng SL-44 cao hơn 45,5% và 54,2% so với đối chứng chỉ lây nhiễm với nấm Rhizoctonia solani (R) và cao hơn 18,2% và 31,8% so với đối chứng không lây nhiễm nấm (CK). Chiều cao cây khi xử lý với SR tăng lần lượt 14,2% và 9,0% so với xử lý R và CK. Thử nghiệm đối kháng in vitro cho thấy SL-44 thể hiện hoạt tính kháng nấm mạnh kháng lại sự phát triển của sợi nấm Rhizoctonia solani, với tỷ lệ ức chế 42,3%. Chủng SL-44 có khả năng phân giải phốt
phát với hàm lượng đạt 60,58 mg/l và tổng hợp IAA đạt 7,5 µg/mL. Bacillus subtilis SL-44 được xem là chủng kiểm soát sinh học tiềm năng đối kháng nấm Rhizoctonia solani gây bệnh trên cây ớt.
Jiang và cộng sự (2018) đã tuyển chọn được hai chủng Bacillus velezensis 5YN8 và DSN012 có khả năng kiểm soát bệnh mốc xám và thúc đẩy tăng trưởng cây ớt [145]. B. velezensis có thể ngăn chặn sự phát triển và hình thành bào tử của Botrytis cinerea (nguyên nhân gây bệnh mốc xám) bằng cách tiết ra một số chất chuyển hóa thứ cấp hoặc giải phóng các hợp chất hữu cơ dễ bay hơi (VOC). Ngoài ra B. velezensis có thể kích thích hệ thống miễn dịch của thực vật đồng thời gia tăng sự tích lũy hydro peroxide và tăng hoạt tính của một số enzyme có trong lá ớt.
Chủng Bacillus velezensis BAC03 có khả năng thúc đẩy sinh trưởng trên chín loại thực vật, bao gồm củ cải, cà rốt, dưa chuột, ớt, khoai tây, bí, cà chua đã được Meng và cộng sự (2016) thử nghiệm trong điều kiện nhà lưới [146]. Kết quả cho thấy BAC03 làm tăng sự phát triển của một số cây được thử nghiệm ở nhiều cấp độ khác nhau trên các bộ phận khác nhau của cây như số lá, khối lượng tươi của lá và rễ. BAC03 còn tạo ra axit indole-3-acetic và amoniac 1-aminocyclopropane-1-carylate deaminase liên quan đến việc thúc đẩy tăng trưởng thực vật. Bằng phương pháp GC- MS, nghiên cứu đã xác định được hai chất dễ bay hơi Acetoin và 2,3-butanediol được giải phóng từ BAC03. Tuy nhiên, chưa có công bố nào về ảnh hưởng của chủng Bacillus velezensis đến sinh trưởng và khả năng kháng bệnh trên cây hồ tiêu.
Bên cạnh đó, chủng Bacillus amyloliquefaciens IBFCBF-1 đã được Zhang và cộng sự (2016) phân lập và tuyển chọn có hiệu quả kiểm soát tốt đối với Phytophthora capsici trong điều kiện nhà lưới [109]. Kết quả cho thấy tỷ lệ bệnh trong ba nghiệm thức (CK1, CK2, T) lần lượt là 61,11, 52,78 và 13,89%. Hơn nữa xử lý với chủng IBFCBF-1 làm tăng đáng kể chiều cao cây, đường kính thân, trọng lượng khô của cây và trọng lượng khô của rễ. So với đối chứng, chiều cao cây tăng 17,3%, đường kính thân tăng 8,7%, khối lượng khô phần trên tăng 38,8% và khối lượng khô của rễ tăng đáng kể 53,8%. Tương tự như vậy chủng Bacillus amyloliquefaciens Y1 giúp cải thiện đáng kể sự đồng hóa dinh dưỡng NPK, mật độ vi khuẩn tổng số có thể nuôi cấy, vi khuẩn sản sinh chitinase và các hoạt tính của chitinase và dehydrogenase trong đất. Chủng B. amyloliquefaciens Y1 có tác động tích cực đến tính chất của đất và có thể được đề xuất làm phân bón sinh học để giảm thiểu việc bón phân trong nông
nghiệp hiện đại.
Tóm lại qua ghi chép theo dõi và phân tích các số liệu thấy rằng các chủng vi khuẩn đều tác động đến sinh trưởng cũng như làm giảm tỷ lệ rễ bệnh, tỷ lệ chết và mật độ Phytophthora sp. gây bệnh chết nhanh trên cây hồ tiêu vườn ươm. Nhưng tổng thể chủng RB.DS29 có tính đồng đều và vượt trội hơn so với các chủng còn lại. Chủng này được lựa chọn cho các nghiên cứu tiếp theo.
3.1.2.2. Tuyển chọn chủng vi sinh vật vùng rễ có khả năng kháng nấm Fusarium trên cây hồ tiêu con trong điều kiện vườn ươm
*Ảnh hưởng của các chủng vi khuẩn đến sinh trưởng của cây hồ tiêu
Sinh trưởng của thực vật bị ảnh hưởng bởi rất nhiều yếu tố môi trường, bao gồm ánh sáng, nhiệt độ, chất dinh dưỡng và vi sinh vật. Vùng xung quanh gốc, thân rễ, tương đối giàu chất dinh dưỡng, vì có đến 40% sản phẩm quang hợp thực vật có thể bị mất từ rễ [147].
Bảng 3.9. Ảnh hưởng của các chủng vi khuẩn vùng rễ đến sinh trưởng thân và lá của cây hồ tiêu vườn ươm sau 120 ngày lây nhiễm với nấm Fusarium oxysporum
Đường kính cây (mm) | Khối lượng tươi (g) | Số lá/ cây hồ tiêu | Diện tích lá (cm2) | Diệp lục a (mg/g) | Diệp lục b (mg/g) | Carotenoid (mg/g) | |
RB.EK2 | 3,17±0,05ab | 17,24±4,63ab | 11,67±0,71a | 36,12±4,51b | 0,55±0,02d | 0,34±0,01b | 0,348±0,01d |
RB.DC16 | 3,17±0,05ab | 15,95±2,59ab | 11,67±1,88a | 38,25±4,91ab | 0,60±0,01bc | 0,39±0,01a | 0,386±0,01bc |
RB.CJ4 | 3,30±0,03a | 18,17±2,39a | 12±1,91a | 40,12±2,81ab | 0,63±0,01ab | 0,40±0,01a | 0,414±0,01a |
RB.CJ12 | 3,30±0,06a | 19,38±3,35a | 11,33±1,23a | 41,37±2,72a | 0,55±0,01d | 0,34±0,01b | 0,380±0,01c |
RB.CJ27 | 3,03±0,24c | 18,35±4,17a | 12,33±0,45a | 38,73±4,50ab | 0,46±0,02e | 0,32±0,02b | 0,325±0,01e |
RB.CJ41 | 3,23±0,07ab | 19,80±2,46a | 12,33±1,42a | 37,38±0,56ab | 0,65±0,00a | 0,42±0,00a | 0,407±0,01ab |
ĐC1 | 3,17±0,14ab | 17,24±2,68ab | 10,67±0,59ab | 40,07±4,34ab | 0,59±0,06c | 0,39±0,04a | 0,384±0,03c |
ĐC2 | 3,1±0,11ab | 12,69±0,65b | 8,67±0,55b | 36,13±0,13b | 0,39±0,01bc | 0,27±0,03c | 0,277±0,01f |
CV% | 3,59 | 16,17 | 11,45 | 8,21 | 3,31 | 5,43 | 3,31 |
P | ** | * | ** | * | ** | ** | ** |
Ghi chú: ĐC1: Đối chứng không lây nhiễm cây hồ tiêu con với Fusarium oxysporum.; ĐC2: Đối chứng lây nhiễm tiêu con với Fusarium oxysporum. * Khác biệt có ý nghĩa thống kê ở mức p<0,05, ** Khác biệt có ý nghĩa thống kê ở mức p<0,01, các chữ cái giống nhau trên cùng một cột thể hiện sự khác biệt không có ý nghĩa thống kê theo trắc nghiệm phân
hạng Duncan’s Multiple Rang Test.
Kết quả bảng 3.9 cho thấy, ở các nghiệm thức xử lý với vi khuẩn vùng rễ đều có ảnh hưởng đến sinh trưởng thân và lá của cây hồ tiêu giai đoạn vườn ươm và có sự khác biệt sự khác biệt về đường kính cây hồ tiêu, số lá trên cây hồ tiêu, diệp lục a, diệp lục b và diệp lục b giữa các nghiệm thức có ý nghĩa ở mức p<0,01. Khi xử lý với các chủng vi khuẩn vùng rễ, đường kính thân tăng 4,10% đến 6,45% (RB.CJ4 và RB.CJ12), số lá tăng 15,56% đến 42,21% (RB.CJ41), diệp lục a tăng từ 10,17% đến 66,67% (RB.CJ41), diệp lục b tăng từ 7,69% đến 55,56% (RB.CJ41), carotenoid tăng từ 7,81% - 49,46% (RB.CJ4) so với đối chứng ĐC2. Trong khi đó, sự khác biệt về khối lượng tươi của thân cây hồ tiêu và diện tích lá giữa các nghiệm thức có ý nghĩa ở mức p<0,05. Các chủng vi khuẩn vùng rễ đã tác động làm gia tăng khối lượng tươi của thân từ 14,85% đến 56,03% (RB.CJ41), diện tích lá từ 3,24% đến 34,5% (RB.CJ12) so với đối chứng ĐC 2 (chỉ lây nhiễm nấm bệnh).
Bảng 3.10. Ảnh hưởng của các chủng vi khuẩn vùng rễ đến sinh trưởng rễ và mật độ vi sinh vật tổng số trong đất của cây hồ tiêu vườn ươm sau 120 ngày lây nhiễm với nấm Fusarium oxysporum
Chiều dài rễ (cm) | Khối lượng rễ tươi(g) | Mật độ vi sinh vật tổng số (x105CFU/g đất) | |
RB.EK2 | 21,81±1,41ab | 1,35±0,44ab | 70,00±1,00bc |
RB.DC16 | 19,34±0,64bc | 1,33±0,20ab | 62,33±1,53c |
RB.CJ4 | 22,48±2,62a | 1,39±0,38ab | 32,33±4,93d |
RB.CJ12 | 21,45±1,00ab | 1,34±0,17ab | 60,00±11,00c |
RB.CJ27 | 21,23±1,74ab | 1,39±0,99ab | 105,00±28,84a |
RB.CJ41 | 22,68±0,90a | 1,66±0,26a | 94,00±6,24b |
ĐC1 | 23,19±1,58a | 1,61±0,22ab | 32,00±7,00d |
ĐC2 | 18,58±0,59c | 1,14 ±0,25b | 21,33±4,04d |
CV% | 7,09 | 19,39 | 25,19 |
P | ** | * | * |
Ghi chú: ĐC1: Đối chứng không lây nhiễm cây hồ tiêu con với Fusarium oxysporum; ĐC2: Đối chứng lây nhiễm tiêu con với Fusarium oxysporum * Khác biệt có ý nghĩa thống kê ở mức p<0,05, ** Khác biệt có ý nghĩa thống kê ở mức p<0,01, các chữ cái giống nhau trên cùng một cột thể hiện sự khác biệt không có ý nghĩa thống kê theo trắc nghiệm phân hạng Duncan’s Multiple Rang Test.
Kết quả bảng 3.10 và hình 3.7 cho thấy, các nghiệm thức xử lý với vi khuẩn vùng rễ đều có ảnh hưởng đến sinh trưởng rễ của cây hồ tiêu giai đoạn vườn ươm. Chiều dài rễ có sự khác biệt có ý nghĩa thống kê giữa các nghiệm thức ở mức p<0,01. Trong các nghiệm thức xử lý vi khuẩn, nghiệm thức RB.CJ4 và RB.CJ41 có chiều dài rễ lớn nhất đạt lần lượt 22,48cm và 22,68cm dẫn đến chiều dài rễ tăng lần lượt 20,99% và 22,07% so với đối chứng lây nhiễm nấm bệnh (ĐC2). Tuy nhiên, sự khác biệt về khối lượng rễ tươi và mật độ vi sinh vật tổng số thì có ý nghĩa ở mức p<0,05. Khối lượng rễ tươi ở các nghiệm thức xử lý vi khuẩn đạt từ 1,33g - 1,66g. Nghiệm thức RB.CJ41 có khối lượng rễ đạt cao nhất, tăng từ 3,1% đến 45,61% so với đối chứng không lây nhiễm với nấm bệnh (ĐC1) và lây nhiễm với nấm bệnh (ĐC2). Bên cạnh đó, mật độ vi sinh vật tổng số (bảng 3.10 và hình 3.8) trong các nghiệm thức có bổ sung vi khuẩn biến động từ 32,33 x 105 đến 105 x 105 CFU/g đều cao hơn so với đối chứng. Nghiệm thức RB.CJ27 có lượng vi sinh vật tổng số cao nhất gấp 3,923 lần so với ĐC 1 và gấp 2,28 lần so với đối chứng ĐC2.

Hình 3.7. Chiều cao cây và chiều dài rễ của cây hồ tiêu vườn ươm
Ghi chú: 1: Nghiệm thức xử lý với chủng vi khuẩn RB.CJ27, 2: nghiệm thức xử lý với vi khuẩn RB.DC16; 3: nghiệm thức xử lý với chủng RB.CJ4; 4: đối chứng 1- không xử lý vi khuẩn, không lây nhiễm nấm bệnh; 5: nghiệm thức xử lý với chủng RB.CJ41; 6: nghiệm thức xử lý với chủng RB.EK2; 7: đối chứng 2 – không xử lý vi khuẩn, lây nhiễm nấm bệnh; 8: nghiệm thức xử lý với chủng RB.CJ12.
Nhìn chung các kết quả đạt được khi đánh giá sinh trưởng của cây hồ tiêu vườn ươm trong nghiên cứu này đều cao hơn so với với nghiên cứu Kodithuwakku và cộng sự (2016) khi tiến hành đánh giá ảnh hưởng của Trichoderma spp., Pseudomonas fluorescens và phân bón vi sinh Arbuscular mycorrhizae ở dạng riêng lẻ và kết hợp với nhau đến sinh trưởng của cây hồ tiêu vườn ươm [147]. Kết quả ghi nhận, nghiệm thức xử lý với hỗn hợp Trichoderma sp. và Pseudomonas fluorescens có diện tích lá cao nhất đạt từ 166,57 cm2 đến 244,47 cm2. Nghiệm thức xử lý với P. fluorescens lại có chiều cao cây, khối lượng rễ tươi và khối lượng rễ khô cao nhất đạt lần lượt 32 cm, 2,27 g và 0,22g. Tuy nhiên, kết quả nghiên cứu của chúng tôi lại thấp hơn nghiên cứu của Dastager và cộng sự (2011) khi tuyển chọn được chủng vi khuẩn vùng rễ có hoạt tính kích thích sinh trưởng cây hồ tiêu là Serratia nematodiphila NII-0928 làm chiều dài rễ cây hồ tiêu vườn ươm tăng 59%, chiều cao thân tăng 77,7% và số rễ tăng 3,6 lần so với đối chứng [148].
Hình 3.8 Mật độ vi sinh vật tổng số trong đất hồ tiêu ở các nghiệm thức
* Ảnh hưởng của chủng vi khuẩn đến tỷ lệ rễ bệnh, mật độ nấm Fusarium cây hồ tiêu vườn ươm
Nấm Fusarium sp. là nguyên nhân chính gây nên bệnh chết chậm trên cây hồ tiêu. Triệu chứng đầu tiên là lá chuyển màu vàng, dễ rụng khi bị lay nhẹ. Cây lá già rụng trước sau đó đến các lá trên. Vì vậy, để đánh giá khả năng kháng nấm Fusarium của các chủng vi khuẩn vùng rễ, nghiên cứu tiến hành xác định tỷ lệ rễ bệnh và tỷ lệ chết của cây hồ tiêu vườn ươm sau 120 ngày xử lý với vi khuẩn và lây nhiễm với nấm bệnh Fusarium.
Kết quả bảng 3.11 cho thấy, các chủng vi khuẩn tuyển chọn đều ảnh hưởng tích cực đến sinh trưởng của cây hồ tiêu trong vườn ươm. Chiều cao cây và số rễ của cây hồ tiêu vườn ươm có sự khác biệt có ý nghĩa thống kê ở mức p<0,05. Chiều cao






